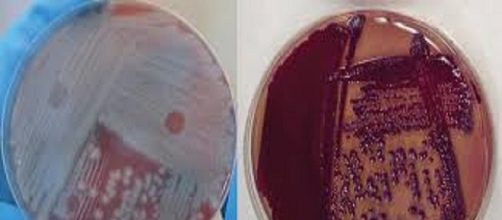
El bacilo del &aacute;ntrax es una mortal bacteria que ha sido usada como arma biol&oacute;gica

Frecuentemente escuchamos hablar del “antrax” y lo peligroso que puede ser, sin embargo pocos conocen a ciencia cierta de qué se trata este terrible y temible enemigo.
Un microorganismo patógeno
El ántrax, es una especie de microorganismo, con forma de bastón o bacilo de Gram positivo, productor de esporas, capsulado e inmóvil, perteneciente al género Bacillus el cual requiere condiciones de oxígeno para sobrevivir, es decir es una bacteria aerobia estricta.
La enfermedad en el humano
El bacilo del ántrax produce una enfermedad conocida como canbunco, carbón xxxx, o simplemente ántrax, que puede afectar a una variedad de especies animales incluido el hombre, la cual tiene un periodo de incubación de 1 y 20 días, aunque frecuentemente la enfermedad se presenta entre 3 y 7 días después de la infección.
En el ser humano se puede presentar en tres formas clínicas diferentes de acuerdo a la forma de transmisión: carbunco cutáneo, inhalatorio o intestinal.
En el ántrax cutáneo, forma más frecuente de la enfermedad, la cual ocurre en el 95 % de los casos, se desarrolla una pápula en el lugar de ingreso o inoculación de la bacteria. Esta lesión suele ulcerarse tornándose de color negro; la diseminación de la bacteria puede causar mortalidad en un porcentaje importante de los casos.
La forma inhalatoria de la enfermedad se caracteriza procudir fiebre y tos seca, seguida de dificultad respiratoria, con sonidos respiratorios, cianosis y septicemia o contaminación del torrente sanguíneo, produciendo la muerte en un corto período en la mayoría de los casos.
El ántrax intestinal es la menos frecuente, produciendo los signos clásico de una gastroenteritis, cursando con fiebre, náuseas, vómitos y diarreas y puede evolucionar rápidamente septicemia la cual genera shock séptico y mortalidad en el 50 % de los enfermos.
Enfermedad en animales
En rumiantes como los caprinos, ovinos y bovinos se produce una forma aguda caracterizada por temblores y dificultad respiratoria, convulsiones y la muerte sobreviene rápidamente en pocos días, obsevrndose hemorragias masivas a través de los orificios corporales naturales.
También se presenta una forma crónica, en la que se producen edemas en el tejido subcutáneo de preferencia en las zonas de declive del cuello, tórax y abdomen.
Uso como arma biológica
Las esporas de este microorganismo se han utilizado como arma biológica, utilizando cepas bacterianas altamente virulentas. Las esporas finamente preparadas, al dispersarse penetran fácilmente a través de las vías respiratorias hacia los alveolos pulmonares ocasionando la forma clínica letal de la enfermedad.
El desarrollo de esta práctica destructiva comenzó durante la Segunda Guerra Mundial,
Su eficacia como arma letal se demostró tras una fuga accidental de sus esporas en una instalación militar soviética en la antigua Sverdlovsk, hoy Ekaterimburgo enel año 1979. La epidemia generada por “el escape” de las esporas de ántrax ocasionó al menos 96 muertes.
Más recientemente, en el año 2001, el ántrax fue utilizado en un ataque terrorista contra los Estados Unidos, en el que se colocaron las esporas de la mortal bacteria en cartas de correo, ocasionando 17 casos de carbón y 5 decesos.